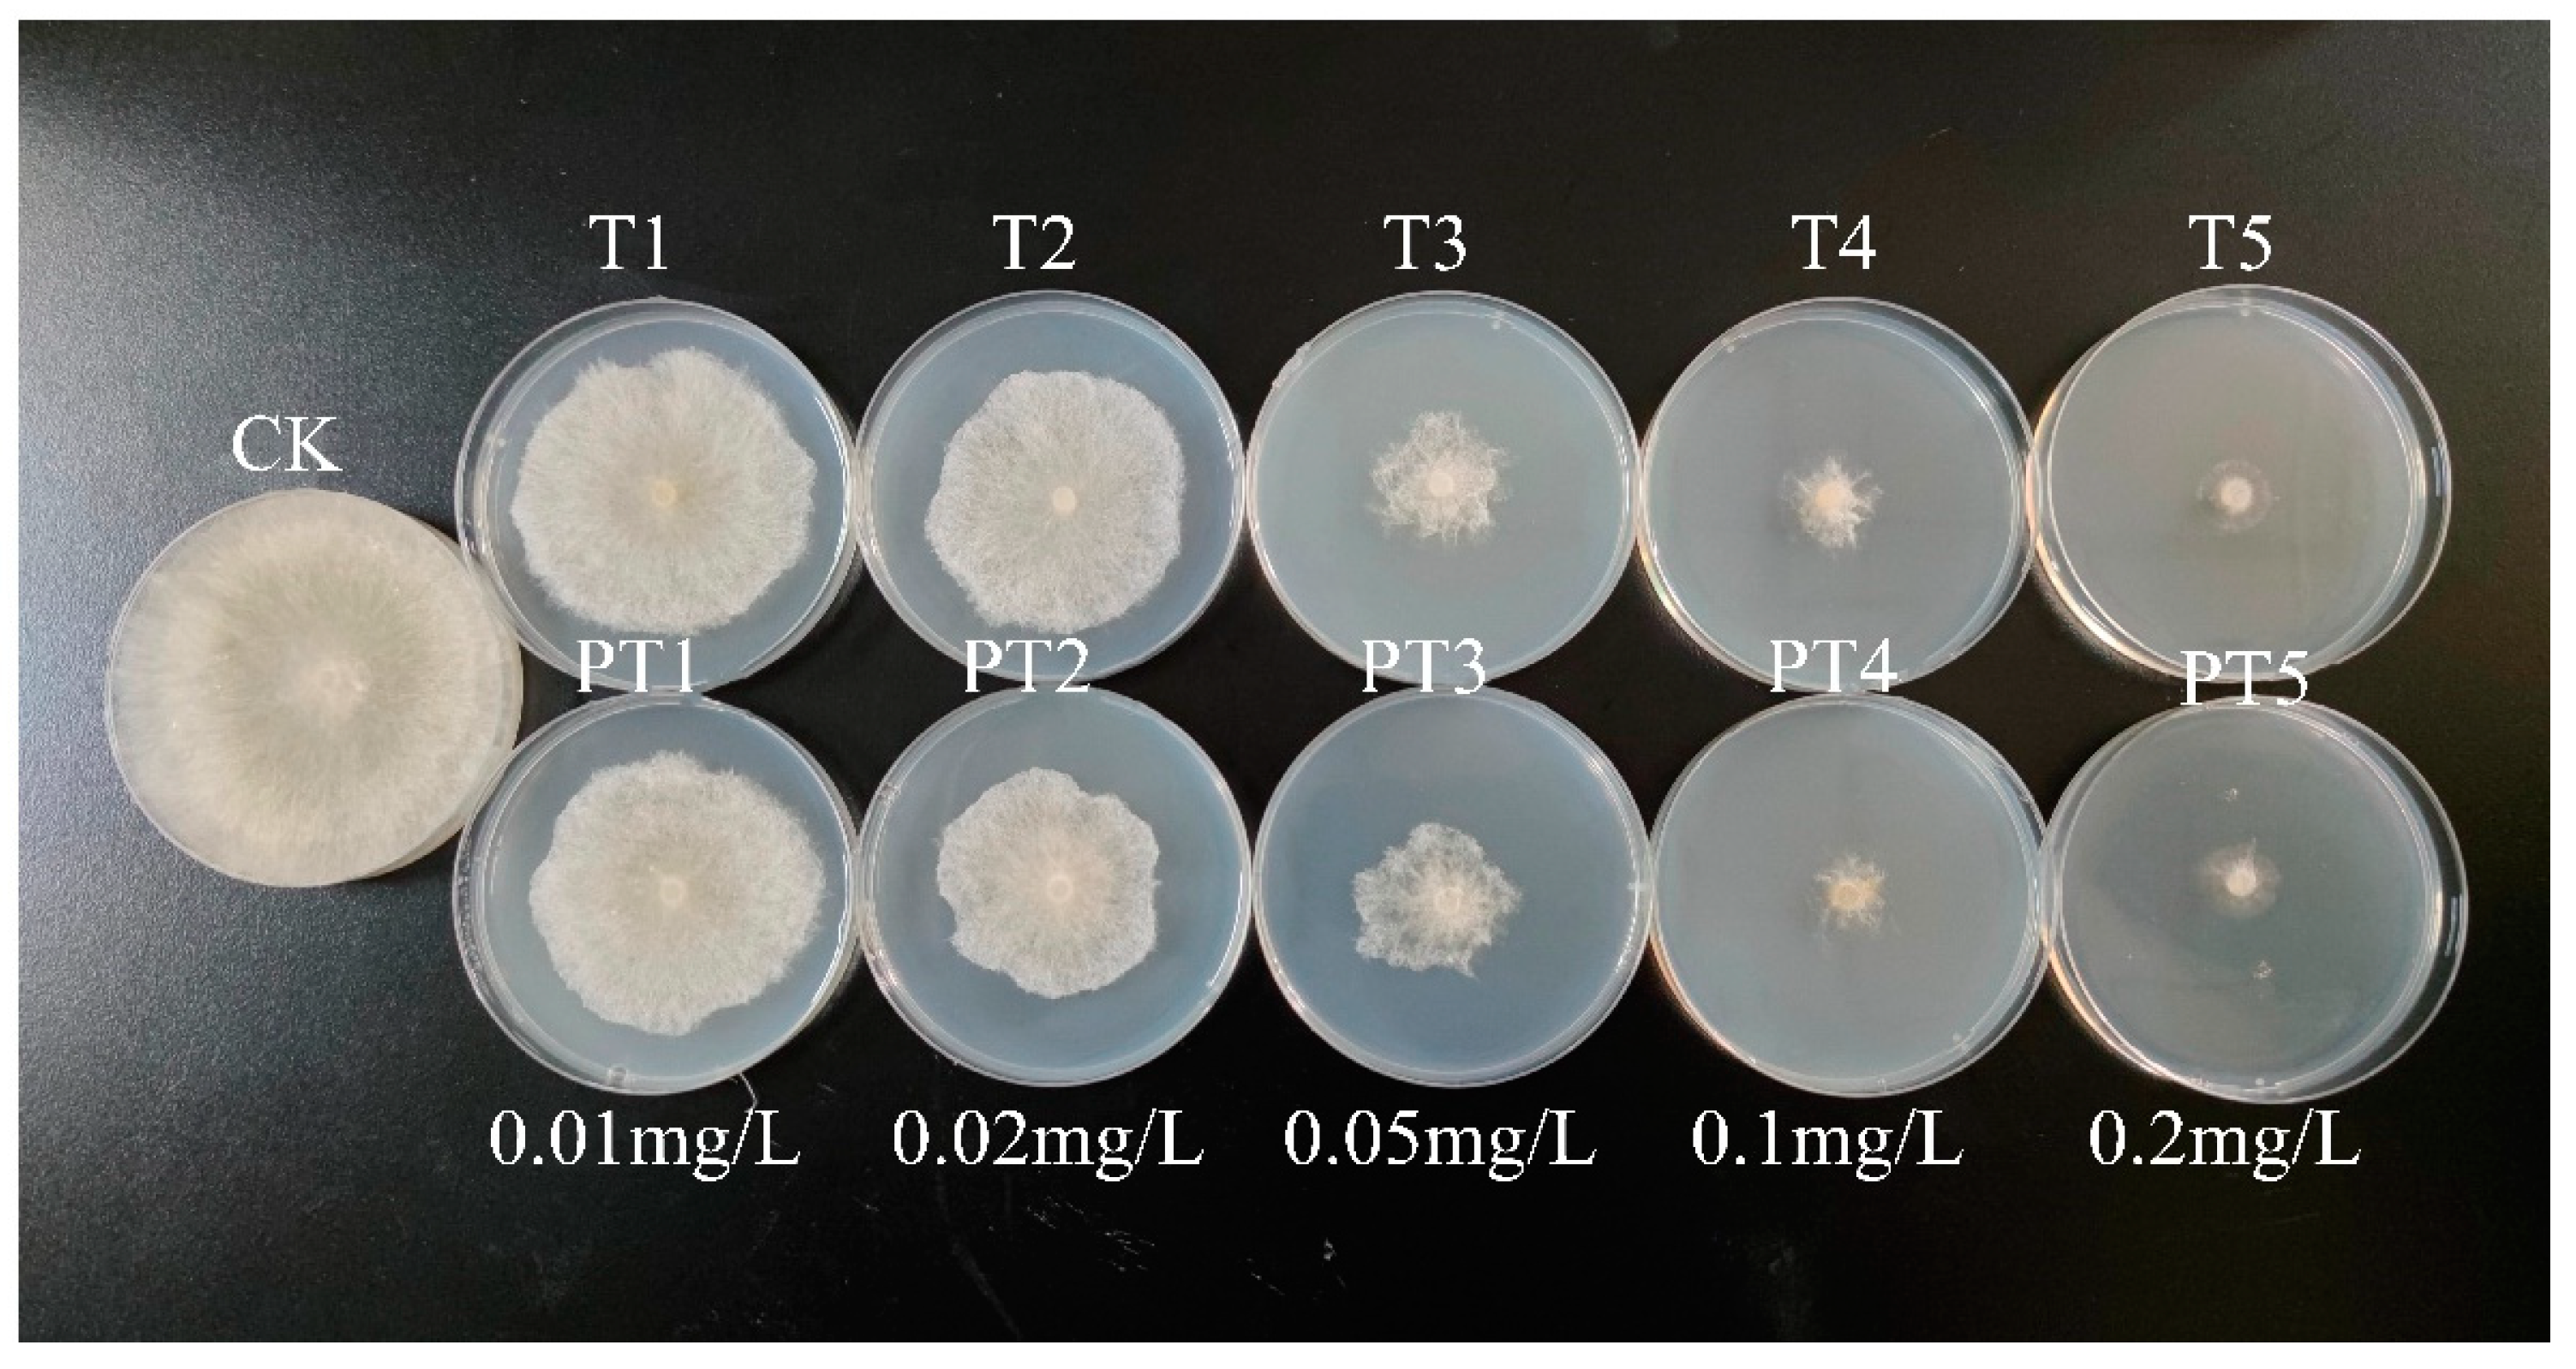
Ijms 24 10121 g005 Ijms 24 10121 g005

Preparation of Thifluzamide Polylactic Acid Glycolic Acid Copolymer Microspheres and Its Effect on the Growth of Cucumber Seedlings
Abstract
1. Introduction
2. Results and Discussion
2.1. Optimization of Preparation Process
2.1.1. Concentration of PVA
2.1.2. Concentration of PLGA
2.1.3. Molecular Weight of PLGA
2.1.4. Oil–Water Ratio
2.1.5. Ultrasonic Power
2.2. Characterization of PT and P
2.3. Bioactivity
2.4. Effects on the Growth of Cucumber Seedlings
2.4.1. Length and Weight
2.4.2. Chlorophyll
2.4.3. Total Phenol, Total Flavonoids, and Protein
3. Materials and Methods
3.1. Materials
3.2. Preparation of PT
3.3. Characterization
3.4. Bioactivity Test of PT
3.5. Cucumber Culture and Treatment
3.6. Determination of Physiological and Biochemical Indexes of PT
4. Conclusions
Supplementary Materials
Author Contributions
Funding
Institutional Review Board Statement
Informed Consent Statement
Data Availability Statement
Conflicts of Interest
Abbreviations
| PLGA | polylactic acid-glycolic acid copolymer |
| PT | thifluzamide polylactic acid-glycolic acid copolymer microspheres |
| P | poly (lactic acid-glycolic acid) copolymer no-load microspheres |
| W | blank comparison |
| T | thifluzamide |
| PVA | polyvinyl alcohol |
| DCM | methylene chloride |
| PDA | potato dextrose agar |
| BCA | bicinchoninic acid |
| SEM | scanning electron microscopy |
| FT-IR | Fourier-transform infrared |
| TGA | thermogravimetric analysis |
| XRD | X-ray diffraction |
| BET | Brunauer–Emmett–Teller |
| HPLC | High-performance liquid chromatography |
References
- Dao, T.T.; Tran, T.T.T.; Nguyen, A.M.; Nguyen, L.N.; Pham, P.T.M.; Tsubota, T.; Nguyen, M.N. Fungicide application can intensify clay aggregation and exacerbate copper accumulation in citrus soils. Environ. Pollut. 2021, 288, 117703. [Google Scholar] [CrossRef]
- Triantafyllidis, V.; Kosma, C.; Karabagias, I.K.; Zotos, A.; Pittaras, A.; Kehayias, G. Fungicides in Europe During the Twenty-first Century: A Comparative Assessment Using Agri-environmental Indices of EU27. Water Air Soil Pollut. 2022, 233, 52. [Google Scholar] [CrossRef]
- Siviter, H.; Bailes, E.J.; Martin, C.D.; Oliver, T.R.; Koricheva, J.; Leadbeater, E.; Brown, M.J.F. Agrochemicals interact synergistically to increase bee mortality. Nature 2021, 596, 389–392. [Google Scholar] [CrossRef]
- Schulz, R.; Bub, S.; Petschick, L.L.; Stehle, S.; Wolfram, J. Applied pesticide toxicity shifts toward plants and invertebrates, even in GM crops. Science 2021, 372, 81–84. [Google Scholar] [CrossRef]
- Singh, K.P.; Mohan, D.; Sinha, S.; Dalwani, R. Impact assessment of treated/untreated wastewater toxicants discharged by sewage treatment plants on health, agricultural, and environmental quality in the wastewater disposal area. Chemosphere 2004, 55, 227–255. [Google Scholar] [CrossRef]
- Peshin, R.; Hansra, B.S.; Nanda, R.; Singh, K.; Sharma, R.; Garg, L.; Bajiya, M.R.; Showkat, A.; Kumar, R.; Yangsdon, S. Pesticides Hazardous Hotspots: Empirical Evidences from North India. Environ. Manag. 2020, 66, 899–915. [Google Scholar] [CrossRef]
- Wu, Y.; Xi, X.; Tang, X.; Luo, D.; Gu, B.; Lam, S.K.; Vitousek, P.M.; Chen, D. Policy distortions, farm size, and the overuse of agricultural chemicals in China. Proc. Natl. Acad. Sci. USA 2018, 115, 7010–7015. [Google Scholar] [CrossRef] [PubMed]
- López, A.; Castro, S.; Andina, M.J.; Ures, X.; Munguía, B.; Llabot, J.M.; Elder, H.; Dellacassa, E.; Palma, S.; Domínguez, L. Insecticidal activity of microencapsulated Schinus molle essential oil. Ind. Crop. Prod. 2014, 53, 209–216. [Google Scholar] [CrossRef]
- Tao, R.; You, C.; Qu, Q.; Zhang, X.; Deng, Y.; Ma, W.; Huang, C. Recent advances in the design of controlled- and sustained-release micro/nanocarriers of pesticide. Environ. Sci. Nano 2023, 10, 351–371. [Google Scholar] [CrossRef]
- Chen, C.; Zhang, G.; Dai, Z.; Xiang, Y.; Liu, B.; Bian, P.; Zheng, K.; Wu, Z.; Cai, D. Fabrication of light-responsively controlled-release herbicide using a nanocomposite. Chem. Eng. J. 2018, 349, 101–110. [Google Scholar] [CrossRef]
- Usman, M.; Farooq, M.; Wakeel, A.; Nawaz, A.; Cheema, S.A.; Rehman, H.U.; Ashraf, I.; Sanaullah, M. Nanotechnology in agriculture: Current status, challenges and future opportunities. Sci. Total. Environ. 2020, 721, 137778. [Google Scholar] [CrossRef]
- Boyandin, A.N.; Sukhanova, A.A.; Ertiletskaya, N.L. Slow-release agricultural pesticide formulations: State of the art. Chim. Techno Acta 2022, 9, 202292S10. [Google Scholar] [CrossRef]
- Frydenberg, T.; Weinell, C.E.; Dam-Johansen, K.; Wallström, E.; Kiil, S. Characterization and Release Mechanisms of Aerogel-Encapsulated Biocide Crystals for Low-Loading and High-Utilization Antifouling Coatings. ACS Omega 2022, 7, 34824–34838. [Google Scholar] [CrossRef] [PubMed]
- Deng, X.; Zhao, P.; Zhou, X.; Bai, L. Excellent sustained-release efficacy of herbicide quinclorac with cationic covalent organic frameworks. Chem. Eng. J. 2020, 405, 126979. [Google Scholar] [CrossRef]
- Kamtsikakis, A.; Kavetsou, E.; Chronaki, K.; Kiosidou, E.; Pavlatou, E.; Karana, A.; Papaspyrides, C.; Detsi, A.; Karantonis, A.; Vouyiouka, S. Encapsulation of Antifouling Organic Biocides in Poly(lactic acid) Nanoparticles. Bioengineering 2017, 4, 81. [Google Scholar] [CrossRef]
- Arzani, F.A.; dos Santos, J.H.Z. Biocides and techniques for their encapsulation: A review. Soft Matter 2022, 18, 5340–5358. [Google Scholar] [CrossRef]
- Goetten de Lima, G.; Wilke Sivek, T.; Matos, M.; Lundgren Thá, E.; de Oliveira, K.M.G.; Rodrigues de Souza, I.; de Morais de Lima, T.A.; Cestari, M.M.; Esteves Magalhães, W.L.; Hansel, F.A.; et al. A biocide delivery system composed of nanosilica loaded with neem oil is effective in reducing plant toxicity of this biocide. Environ. Pollut. 2022, 294, 118660. [Google Scholar] [CrossRef]
- Zhao, P.; Cao, L.; Wang, C.; Zheng, L.; Li, Y.; Cao, C.; Huang, Q. Metabolic pathways reveal the effect of fungicide loaded metal-organic frameworks on the growth of wheat seedlings. Chemosphere 2022, 307, 135702. [Google Scholar] [CrossRef]
- Yusoff, S.N.M.; Kamari, A.; Aljafree, N.F.A. A review of materials used as carrier agents in pesticide formulations. Int. J. Environ. Sci. Technol. 2016, 13, 2977–2994. [Google Scholar] [CrossRef]
- Zhou, J.; Zhai, Y.; Xu, J.; Zhou, T.; Cen, L. Microfluidic preparation of PLGA composite microspheres with mesoporous silica nanoparticles for finely manipulated drug release. Int. J. Pharm. 2021, 593, 120173. [Google Scholar] [CrossRef]
- Kaseem, M.; Hamad, K.U.; Rehman, Z. Review of Recent Advances in Polylactic Acid/TiO2 Composites. Materials 2019, 12, 3659. [Google Scholar] [CrossRef]
- Tyler, B.; Gullotti, D.; Mangraviti, A.; Utsuki, T.; Brem, H. Polylactic acid (PLA) controlled delivery carriers for biomedical applications. Adv. Drug Deliv. Rev. 2016, 107, 163–175. [Google Scholar] [CrossRef]
- Ren, S.; Wang, C.; Guo, L.; Xu, C.; Wang, Y.; Sun, C.; Cui, H.; Zhao, X. Preparation and Sustained-Release Performance of PLGA Microcapsule Carrier System. Nanomaterials 2021, 11, 1758. [Google Scholar] [CrossRef]
- Hood, E.; Simone, E.; Wattamwar, P.; Dziubla, T.; Muzykantov, V. Nanocarriers for vascular delivery of antioxidants. Nanomedicine 2011, 6, 1257–1272. [Google Scholar] [CrossRef]
- Eliaz, R.E.; Kost, J. Characterization of a polymeric PLGA-injectable implant delivery system for the controlled release of proteins. J. Biomed. Mater. Res. 2000, 50, 388–396. [Google Scholar] [CrossRef]
- Chen, C.; Wang, X.; Yin, S.; Wang, C.; Ren, X.; Gao, Q.; Cao, H. Thifluzamide, Fludioxonil, and Clothianidin as Seed Treatment Can Efficiently Control Major Soil-Borne Diseases, Aphids (Aphidoidea spp.), and Residue Distribution in the Field. Agronomy 2022, 12, 2330. [Google Scholar] [CrossRef]
- Ren, X.-X.; Chen, C.; Ye, Z.-H.; Su, X.-Y.; Xiao, J.-J.; Liao, M.; Cao, H.-Q. Development and Application of Seed Coating Agent for the Control of Major Soil-Borne Diseases Infecting Wheat. Agronomy 2019, 9, 413. [Google Scholar] [CrossRef]
- Yang, Y.; Liu, W.; Li, D.; Qian, L.; Fu, B.; Wang, C. Altered glycometabolism in zebrafish exposed to thifluzamide. Chemosphere 2017, 183, 89–96. [Google Scholar] [CrossRef] [PubMed]
- Alvarez-Lorenzo, C.; Mayo-Olveira, F.; Barbosa, S.; Taboada, P.; Concheiro, A. Poly(vinyl alcohol) triggers Au nanoparticles formation for near-infrared radiation-responsive gels and nanofibers. J. Appl. Polym. Sci. 2019, 137, 48811. [Google Scholar] [CrossRef]
- Suganuma, K.; Horiuchi, K.; Matsuda, H.; Cheng, H.N.; Aoki, A.; Asakura, T. NMR analysis and chemical shift calculations of poly(lactic acid) dimer model compounds with different tacticities. Polym. J. 2012, 44, 838–844. [Google Scholar] [CrossRef]
- Zorba, T.; Chrissafis, K.; Paraskevopoulos, K.M.; Bikiaris, D.N. Synthesis, characterization and thermal degradation mechanism of three poly(alkylene adipate)s: Comparative study. Polym. Degrad. Stab. 2007, 92, 222–230. [Google Scholar] [CrossRef]
- Papadopoulos, L.; Magaziotis, A.; Nerantzaki, M.; Terzopoulou, Z.; Papageorgiou, G.Z.; Bikiaris, D.N. Synthesis and characterization of novel poly(ethylene furanoate-co-adipate) random copolyesters with enhanced biodegradability. Polym. Degrad. Stab. 2018, 156, 32–42. [Google Scholar] [CrossRef]
- Krieger-Liszkay, A.; Krupinska, K.; Shimakawa, G. The impact of photosynthesis on initiation of leaf senescence. Physiol. Plant. 2019, 166, 148–164. [Google Scholar] [CrossRef] [PubMed]
- Robinson, K.N.; Kalebich, C.; Fellows, G.M. Effects of Foliar Fungicide Application on the Growing Corn Plant. J. Anim. Sci. 2016, 94 (Suppl. S2), 113. [Google Scholar] [CrossRef]
- Zuntini, B.; Alvarez, R.d.C.F.; Theodoro, G.d.F.; Zuffo, A.M. Effect of adding fungicide to mixtures of triazoles and strobilurins in the control of downy mildew and Asian soybean rust. Pesqui. Agropecuária Trop. 2019, 49, 1983–4063. [Google Scholar] [CrossRef]
- Xia, X.J.; Huang, Y.Y.; Wang, L.; Huang, L.F.; Yu, Y.L.; Zhou, Y.H.; Yu, J.Q. Pesticides-induced depression of photosynthesis was alleviated by 24-epibrassinolide pretreatment in Cucumis sativus L. Pestic. Biochem. Physiol. 2006, 86, 42–48. [Google Scholar] [CrossRef]
- Nason, M.A.; Farrar, J.; Bartlett, D. Strobilurin fungicides induce changes in photosynthetic gas exchange that do not improve water use efficiency of plants grown under conditions of water stress. Pest Manag. Sci. 2007, 63, 1191–1200. [Google Scholar] [CrossRef]
- Mohamed, H.I.; Akladious, S.A. Changes in antioxidants potential, secondary metabolites and plant hormones induced by different fungicides treatment in cotton plants. Pestic. Biochem. Physiol. 2017, 142, 117–122. [Google Scholar] [CrossRef]
- Kalisz, A.; Huska, D.; Jurkow, R.; Dvorak, M.; Klejdus, B.; Caruso, G.; Sekara, A. Nanoparticles of Cerium, iron, and Silicon Oxides Change the Metabolism of Phenols and Flavonoids in Butterhead Lettuce and Sweet Pepper Seedlings. Environ. Sci. 2021, 8, 1945–1959. [Google Scholar] [CrossRef]
- Muscolo, A.; Panuccio, M.R.S.; Sidari, M. The effect of phenols on respiratory enzymes in seed germination. Plant Growth Regul. 2001, 35, 31–35. [Google Scholar] [CrossRef]
- Wang, Y.; Li, P.; Kong, L. Chitosan-Modified PLGA Nanoparticles with Versatile Surface for Improved Drug Delivery. AAPS PharmSciTech 2013, 14, 585–592. [Google Scholar] [CrossRef] [PubMed]
- Pooja, D.; Tunki, L.; Kulhari, H.; Reddy, B.B.; Sistla, R. Optimization of solid lipid nanoparticles prepared by a single emulsification-solvent evaporation method. Data Brief 2016, 6, 15–19. [Google Scholar] [CrossRef] [PubMed]
- Tsachouridis, K.; Christodoulou, E.; Zamboulis, A.; Michopoulou, A.; Barmpalexis, P.; Bikiaris, D.N. Evaluation of poly(lactic acid)/ and poly(lactic-co-glycolic acid)/ poly(ethylene adipate) copolymers for the preparation of paclitaxel loaded drug nanoparticles. J. Drug Deliv. Sci. Technol. 2022, 77, 103918. [Google Scholar] [CrossRef]
- Zhao, P.; Cao, L.; Ma, D.; Zhou, Z.; Huang, Q.; Pan, C. Translocation, distribution and degradation of prochloraz-loaded mesoporous silica nanoparticles in cucumber plants. Nanoscale 2018, 10, 1798. [Google Scholar] [CrossRef] [PubMed]

Disclaimer/Publisher’s Note: The statements, opinions and data contained in all publications are solely those of the individual author(s) and contributor(s) and not of MDPI and/or the editor(s). MDPI and/or the editor(s) disclaim responsibility for any injury to people or property resulting from any ideas, methods, instructions or products referred to in the content. |
© 2023 by the authors. Licensee MDPI, Basel, Switzerland. This article is an open access article distributed under the terms and conditions of the Creative Commons Attribution (CC BY) license (https://creativecommons.org/licenses/by/4.0/).
Share and Cite
Li, Y.; Wang, C.; Deng, X.; Cai, R.; Cao, L.; Cao, C.; Zheng, L.; Zhao, P.; Huang, Q. Preparation of Thifluzamide Polylactic Acid Glycolic Acid Copolymer Microspheres and Its Effect on the Growth of Cucumber Seedlings. Int. J. Mol. Sci. 2023, 24, 10121. https://doi.org/10.3390/ijms241210121
Li Y, Wang C, Deng X, Cai R, Cao L, Cao C, Zheng L, Zhao P, Huang Q. Preparation of Thifluzamide Polylactic Acid Glycolic Acid Copolymer Microspheres and Its Effect on the Growth of Cucumber Seedlings. International Journal of Molecular Sciences. 2023; 24(12):10121. https://doi.org/10.3390/ijms241210121
Chicago/Turabian StyleLi, Yuanyuan, Chaojie Wang, Xile Deng, Runze Cai, Lidong Cao, Chong Cao, Li Zheng, Pengyue Zhao, and Qiliang Huang. 2023. "Preparation of Thifluzamide Polylactic Acid Glycolic Acid Copolymer Microspheres and Its Effect on the Growth of Cucumber Seedlings" International Journal of Molecular Sciences 24, no. 12: 10121. https://doi.org/10.3390/ijms241210121
APA StyleLi, Y., Wang, C., Deng, X., Cai, R., Cao, L., Cao, C., Zheng, L., Zhao, P., & Huang, Q. (2023). Preparation of Thifluzamide Polylactic Acid Glycolic Acid Copolymer Microspheres and Its Effect on the Growth of Cucumber Seedlings. International Journal of Molecular Sciences, 24(12), 10121. https://doi.org/10.3390/ijms241210121

